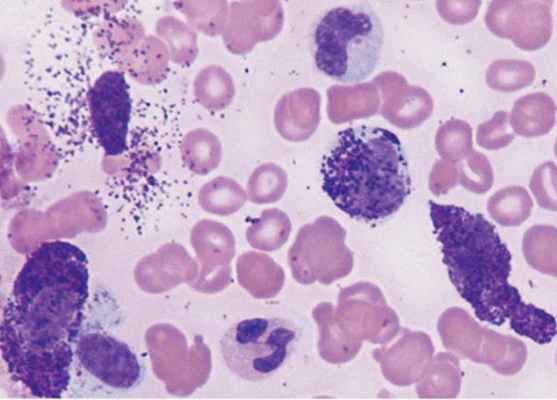

Лучевая диагностика мастоцитоза
Добавил пользователь Morpheus Обновлено: 14.12.2025
Крапивница - острое или хроническое заболевание, часто сопровождающееся зудом и проявляющееся эритематозными (красными, розовыми), безболезненными, волдырными высыпаниями, которые обычно исчезают в течение 24 часов и оставляют после себя чистую кожу.
К характерным особенностям крапивницы относятся:
- высыпания в виде волдырей, пятен и отеков,
- наличие зуда (может быть только зуд без сыпи или сыпь без зуда),
- безболезненность сыпи (сопутствующий отек Квинке может быть болезненным),
- отдельные высыпания исчезают в течение 1 дня, оставляя после себя «чистую кожу». Если отдельные волдыри держатся более 1 дня и/или после них остается шелушение, пигментация и т.п. остаточные явления, то это может быть другое заболевание, напоминающее крапивницу, например, уртикарный васкулит.
Важно
Крапивница может сопровождаться отеком Квинке (ангиоотек, старое название - ангионевротический отек). Ангиоотек - отек, вовлекающий в патологический процесс глубокие слои кожи. По статистике в 50% случаев крапивница протекает изолированно, у 40% больных крапивницей развивается отек Квинке и у 10% пациентов возникает ангиоотек без крапивницы.
Некоторые пациенты искренне заблуждаются, считая, что отек Квинке - это только отек лица или горла. Ангиоотек действительно часто возникает в области лица, но это не значит, что он не может появиться на кистях, стопах и других участках тела.
Распространенность крапивницы. Крапивница очень распространенное заболевание, которым страдают 15-25% людей всего мира (возникает как минимум 1 эпизод в течение жизни), при этом острая крапивница составляет более 60% всех случаев.
Причины возникновения крапивницы
Крапивница не всегда бывает аллергической, как считают многие. Большинство случаев заболевания связано с действием различных факторов, многие из которых в настоящее время, вообще, неизвестны. Тем не менее, ученые предполагают, что крапивница нередко протекает лишь как «симптом» другого заболевания, являющегося ее причиной. И это действительно так. Крапивницу часто отмечают и связывают с инфекциями, заболеваниями желудочно-кишечного тракта, болезнями печени, поджелудочной и щитовидной железы, паразитарными инвазиями, ревматическими и аутоиммунными заболеваниями, опухолями и т.д.
Важно, что наиболее частые причины острой и хронической крапивницы принципиально различаются.
Причины острой крапивницы
Острая крапивница часто бывает аллергической и обычно развивается из-за реакций гиперчувствительности на определенный аллерген из внешней среды. Таким образом, большинство случаев острой крапивницы и/или ангиоотека являются аллергическими и протекают по иммунному механизму, связанному с синтезом антител класса Е (IgE). Наиболее частыми аллергенами крапивницы являются:
- лекарственные средства, например, антибиотики (пенициллины, сульфониламиды и другие), нестероидные противовоспалительные препараты (НПВП, такие как аспирин), миорелаксанты, диуретики и другие;
- пищевые продукты (как при прямом контакте с кожей, так и при употреблении внутрь; например, молоко, яйца, арахис, орехи, морепродукты, рыба);
- укусы / ужаления насекомых;
- контакт с другими аллергенами и веществами (например, латексом, резиной, слюной животных, растениями и т.д.).
Иногда острая крапивница протекает по другим иммунным механизмам (не связанным с продукцией IgE):
- при применении определенного вида ЛС (например, опиодов, бета-блокаторов, ванкомицина, НПВП) или употребления пищевых продуктов;
- использование рентгеноконтрастных веществ;
- при острых вирусных инфекциях (особенно у детей);
- по другим причинам (ревматические заболевания, гормональные нарушения и т.д.)
К сожалению, в 70-90% случаев причина хронической рецидивирующей крапивницы у взрослых больных остается неизвестной и заболевание считается идиопатическим, т. е. без выявленной причины. У детей хроническая крапивница бывает намного реже, чем у взрослых и ее причина выявляется намного чаще.
У 30-50% больных хроническая крапивница / ангиоотек имеют аутоиммунную природу и могут быть связаны с другими аутоиммунными заболеваниями, например, с болезнью щитовидной железы - аутоиммунным тиреоидитом. Ученые считают, что в около 40-60% случаев хронической крапивницы с невыявленной причиной заболевание связано с известными или пока неизвестными науке аутоиммунными процессами, во всех остальных – является «истинным» идиопатическим (т.е. без выявленной причины и без аутоиммунной подоплеки). Кроме этого, есть заболевания, которые в настоящее время перестали относить к крапивнице, хотя они очень на нее похожи (например, уртикарный васкулит, кожный мастоцитоз – пигментная крапивница и другие).
Признаки крапивницы
- зуд,
- волдыри,
- пятна,
- покраснение кожи (эритема),
- возможен отек Квинке,
- иногда в области отека отмечается натяжение кожи, некоторая болезненность,
- жжение, боль в области высыпаний более характерна для уртикарного васкулита.
Диагностика крапивницы
Несмотря на схожесть симптомов подход к диагностике при острой и хронической крапивнице отличается. Лабораторные исследования необходимы в некоторых случаях для выявления причины хронической и интермиттирующей (эпизодической) острой крапивницы. В большинстве случаев диагноз основывается на анамнезе (истории заболевания) и осмотре пациента.
Обращение/направление к специалисту (аллергологу-иммунологу) необходимо во многих случаях хронической крапивницы для составления диагностического плана (поиск основной причины заболевания) и подбора лечения.
При подозрении на аллергическую крапивницу возможно проведение аллергологического исследования (кожные тесты и определение специфических антител в крови). Для исключения сопутствующей патологии при хронической крапивнице/ангиоотеке спектр обследования определяется аллергологом в каждом конкретном случае индивидуально.
К сожалению, причина хронической крапивницы и/или ангиоотека в большинстве случаев даже после обширного обследования не выявляется. Но такой пациент остается под дальнейшим врачебным наблюдением для обнаружения симптомов заболевания, являющегося причиной крапивницы, коррекции терапии в ожидании спонтанной ремиссии (излечения) крапивницы.
Заболевания похожие на крапивницу
Существует несколько заболеваний, симптомы которых напоминают крапивницу:
- уртикарный васкулит,
- пигментная крапивница (мастоцитоз),
- крапивница во время беременности,
- реакции на лекарства,
- атопический дерматит,
- контактный дерматит,
- мультиформная эритема,
- анафилактоидная пурпура,
- чесотка.
Лечение крапивницы
Лекарства «от крапивницы», в частности антигистаминные таблетки, позволяют избавить пациента от мучительных проявлений заболевания, приводят к повышению качества жизни. К основным методам и видам лечения крапивницы относятся:
- антигистаминные препараты: действующие на Н1-рецепторы (1 и 2 поколение) и Н2-рецепторы гистамина. Антигистаминные препараты - препараты первого выбора для лечения как острой, так и хронической крапивницы. Иммуномодуляторы (например, преднизолон, циклоспорин и др.) показаны лишь небольшому количеству пациентов с хронической крапивницей,
- иммуномодуляторы (в т.ч. глюкокортикостероидные лекарства (т.н. «гормональные» средства, циклоспорин и другие),
- антагонисты лейкотриеновых рецепторов,
- некоторые другие.
Ангиоотек в области лица, горла или шеи может вызывать нарушение проходимости дыхательных путей и может требовать немедленного введения адреналина (эпинефрина).
Лечение хронической крапивницы зависит от того, выявлено ли первичное заболевание, являющееся ее причиной, или нет. Если такое заболевание выявлено, то в первую очередь проводится его лечение.
Оформите заявку на сайте, мы свяжемся с вами в ближайшее время и ответим на все интересующие вопросы.
Лучевая диагностика мастоцитоза
Лучевая диагностика мастоцитоза
а) Визуализация мастоцитоза:
• Кожная форма мастоцитоза (пигментная крапивница) является наиболее распространенной
• Системный мастоцитоз: пролиферация тучных клеток в коже, костях, лимфатических узлах, внутренних органах брюшной полости
• Желудочно-кишечный тракт поражается в 16% случаев:
о Пептическая язвенная болезнь и мальабсорбция
о Двенадцатиперстная кишка и тонкая кишка: утолщение складок, уменьшение времени транзита
о Узловые изменения слизистой оболочки (узелки размерами 2-3 мм в виде «песчинок»)
- Дилятация тонкой кишки с наличием жидкостного содержимого в просвете
• Гепатомегалия (в 40% случаев у взрослых)
• Желчные пути: инфильтрация стенок, неравномерные стриктуры
• Спленомегалия с наличием узловых депозитов (в 50% случаев)
• Лимфаденопатия, утолщение сальника и брыжейки
• Очаги поражения склеротического или литического характера в костях осевого скелета
• Сцинтиграфия костей: литические очаги, остеопороз либо остеосклероз
(Слева) На аксиальной КТ без контрастного усиления у пожилого мужчины с нарушением функции печени и диареей определяются диффузные склеротические очаги в костях осевого скелета. Обратите внимание на неравномерное, умеренно выраженное расширение внутрипеченочных желчных протоков, а также спленомегалию.
(Справа) На аксиальной КТ без контраста у этого же пациента визуализируется растянутая тонкая кишка с утолщенной стенкой и наличием жидкости в просвете. Пациенту была выполнена биопсия стенки желчного протока и кишечника, обнаружена инфильтрация стенки большим количеством тучных клеток, что является диагностическим признаком системного мастоцитоза. (Слева) На КТ у этого же пациента с системным мастоцитозом определяются распространенные склеротические изменения всего осевого скелета наряду с утолщением стенки растянутой тонкой кишки и наличием жидкости в ее просвете.
(Справа) На рентгенограмме тонкой кишки с контрастом, полученной у пациента с подтвержденным мастоцитозом, определяются распространенные патологические изменения тонкой кишки, в т. ч. замещение нормальной «картины» складок на узловую.
б) Дифференциальная диагностика:
• Карциноидная опухоль
• Синдром Золлингера-Эллисона
• Целиакия
• Состояния, сопровождающиеся мальабсорбцией
• Первичный склерозирующий холангит (при поражении желчных путей)
в) Патология:
• Системный мастоцитоз является одним из миелопролиферативных неопластических состояний:
о Наряду с полицитемией, миелофиброзом, хроническим миелоидным лейкозом и т. д.
г) Клинические особенности:
• Осложнения:
о Частота злокачественной трансформации с развитием злокачественных опухолей системы крови составляет 30%
• Лечение: эпинефрин, стероидные гормоны, блокаторы Н1- и Н2-гистаминовых рецепторов, ингибиторы протонной помпы, антихолинергические средства; химиотерапия:
о Трансплантация гемопоэтических стволовых клеток является многообещающим способом терапии
Что такое мастоцитоз - простыми словами

Мастоцитоз - редкое заболевание, вызванное скоплением избыточного количества тучных клеток в тканях организма. Выделяют 2 основных типа мастоцитоза:
- кожный мастоцитоз, который в основном поражает детей, когда тучные клетки собираются в коже, но не встречаются в больших количествах в других частях тела;
- системный мастоцитоз, который в основном поражает взрослых, когда тучные клетки собираются в тканях тела, таких как кожа, внутренние органы и кости.
Тучные клетки производятся в костном мозге, губчатой ткани, обнаруженной в полых центрах некоторых костей, и живут дольше, чем нормальные клетки. Они являются важной частью иммунной системы и помогают бороться с инфекциями. Когда тучные клетки обнаруживают вещество, которое вызывает аллергическую реакцию (аллерген), они выделяют гистамин и другие химические вещества в кровоток. Гистамин заставляет кровеносные сосуды расширяться, а окружающую кожу зудеть и опухать. Такое состояние также может привести к спазму и сужению дыхательных путей и скоплению слизи в них.
Симптомы мастоцитоза
Симптомы мастоцитоза могут различаться в зависимости от типа.
Симптомы кожного мастоцитоза
Наиболее частым признаком кожного мастоцитоза являются аномальные новообразования на коже. Типы поражений кожи могут включать:
- небольшие участки кожи, меняющие цвет (пятна);
- небольшие твердые выпуклые шишки (папулы);
- более крупные выпуклые красные шишки (узелки);
- большие приподнятые участки кожи, заметные на ощупь (бляшки);
- волдыри, которые в основном поражают маленьких детей с мастоцитомами (опухолями, состоящими из тучных клеток) или диффузным кожным мастоцитозом (редкая форма кожного мастоцитоза);
- пигментная крапивница - обычно поражения имеют цвет от желто-коричневого до красновато-коричневого и могут иметь размер от 1 мм до нескольких сантиметров.
Поражения обычно развиваются на теле, а на голове, шее и конечностях – значительно реже. Количество поражений, которые развиваются на коже, может широко варьироваться, например, возможно развитие только одного очага или более 1000. Поглаживание пораженных участков кожи может вызвать отек, зуд и покраснение пораженного участка.
Симптомы системного мастоцитоза
Некоторые пациенты с системным мастоцитозом могут испытывать эпизоды тяжелых симптомов, которые длятся 15-30 минут, часто со специфическими триггерами. Наиболее частые симптомы, наблюдаемые во время приступа:
- приливы - описываются как ощущение сухого тепла, как при потоотделении;
- сильное или учащенное сердцебиение;
- головная боль;
- одышка;
- грудная боль;
- плохое самочувствие;
- тошнота, понос;
- потеря аппетита;
- боль в суставах;
- изменения психического состояния - например, спутанность сознания, раздражительность, плохая концентрация внимания и нарушение памяти;
- частое мочеиспускание или боль при мочеиспускании.
После того, как эпизод проходит, пациент, вероятно, будет чувствовать себя вялым в течение нескольких часов. Эпизоды вызваны тем, что тучные клетки внезапно высвобождают чрезмерное количество гистамина, и обычно это происходит после воздействия определенных триггеров:
- физические факторы - жара, перегрев, холод, усталость и физические нагрузки; эмоциональные факторы - стресс и волнение;
- укусы насекомых;
- инфекция - например, простуда или грипп;
- алкоголь;
- определенные лекарства - такие как ибупрофен, аспирин и антибиотики; определенные продукты - такие как сыр, моллюски и специи.
В более тяжелых случаях мастоцитоза могут возникнуть следующие симптомы:
- потеря веса;
- опухоль лимфатических узлов;
- отек печени, который может вызвать желтуху;
- отек селезенки.
Некоторые пациенты с тяжелыми симптомами мастоцитоза испытывают внезапное падение артериального давления во время приступа, что может вызвать ряд сопутствующих состояний:
- головокружение;
- обморок;
- помутнение зрения;
- спутанность сознания;
- общая слабость.
Пациенты с мастоцитозом имеют повышенный риск развития тяжелой и опасной для жизни аллергической реакции, известной как анафилаксия. Высокий риск анафилаксии вызван аномально большим количеством тучных клеток и их способностью выделять большое количество гистамина в кровь. Важно обратить внимание на начальные симптомы анафилаксии, которые включают:
- кожный зуд или красная кожная сыпь;
- опухшие глаза, губы, руки и ноги;
- чувство головокружения или обморока;
- сужение дыхательных путей, что может вызвать хрипы и затрудненное дыхание; боль в животе;
- тошнота.
Состояние анафилаксии может угрожать жизни больного, поэтому при первых же признаках необходимо обратиться за неотложной помощью.
Виды мастоцитоза
Существует 3 подтипа системного мастоцитоза в зависимости от тяжести течения:
- Вялотекущий мастоцитоз - симптомы обычно от слабых до умеренных и варьируются от человека к человеку; вялотекущий мастоцитоз составляет около 90% случаев системного мастоцитоза у взрослых.
- Агрессивный мастоцитоз – тип заболевания, когда тучные клетки размножаются во внутренних органах, таких как селезенка, печень и пищеварительная система; симптомы более обширны и серьезны, хотя поражения кожи встречаются реже. Системный мастоцитоз с ассоциированным заболеванием крови (гематологическим), при котором также развивается состояние, которое влияет на клетки крови, например, хронический лейкоз.
Причины мастоцитоза
Причины мастоцитоза до конца не известны, но считается, что существует связь с изменением генов, известным как мутация KIT. Мутация KIT делает тучные клетки более чувствительными к воздействию сигнального белка, называемого фактором стволовых клеток, который играет важную роль в стимулировании производства и выживания определенных клеток внутри костного мозга. В очень немногих случаях мастоцитоза мутация KITпередается через семьи. Однако в большинстве случаев генный дефект происходит без видимой причины.
Диагностика мастоцитоза
Физикальное обследование кожи - это первый этап диагностики кожного мастоцитоза. Дерматолог проверяют для этого признак Дарье: необходимо потереть пораженные участки кожи, чтобы увидеть, не покраснели ли они, не воспалились и не зудят ли. Обычно можно подтвердить диагноз кожного мастоцитоза, проведя биопсию, при которой берется небольшой образец кожи и проверяется на наличие тучных клеток.
Для подтверждения системного мастоцитоза обычно используются следующие тесты:
- анализы крови, включая развернутый анализ крови и измерение уровня триптазы в крови; чтобы выявить увеличение печени и селезенки;
- DEXA-сканирования для измерения плотности костной ткани;
- тест биопсии костного мозга.
Диагноз системного мастоцитоза обычно ставится при обнаружении типичных изменений при биопсии костного мозга.
Лечение мастоцитоза
От мастоцитоза нет специфического лекарства, поэтому цель лечения - попытаться облегчить симптомы. Варианты лечения будут зависеть от типа заболевания и тяжести его симптомов.
Легкие и средние случаи кожного мастоцитоза можно лечить с помощью местных кортикостероидов в течение короткого времени – до 6 недель. Стероиды уменьшают количество тучных клеток, которые могут выделять гистамин и вызывать воспаление кожи. Побочные эффекты стероидного крема при чрезмерном использовании включают:
- истончение кожи, что иногда может привести к стойким растяжкам;
- временное уменьшение пигментации кожи;
- пораженный участок кожи легко покрывается синяками.
Наносить крем стоит только на участки кожи с поражениями, чтобы снизить риск побочных эффектов.
Если такие симптомы, как зуд, особенно серьезны, могут быть назначены таблетки кортикостероидов (пероральные кортикостероиды) на краткосрочной основе. Короткий курс приема таблеток также может быть рекомендован, если у пациента есть боль в костях, вызванная мастоцитозом или тяжелой аллергической реакцией. Побочные эффекты пероральных кортикостероидов включают:
- повышение аппетита;
- увеличение веса;
- бессонница;
- задержка жидкости;
- изменения настроения, например, чувство раздражительности или беспокойства.
Антигистаминные препараты также можно использовать для лечения симптомов кожного или вялотекущего мастоцитоза, таких как покраснение кожи и зуд. Антигистаминные препараты - это лекарства, которые блокируют действие гистамина, и часто используются для лечения аллергических состояний. Побочные эффекты некоторых классических антигистаминных препаратов включают:
- головная боль;
- сухость во рту сухость слизистой носа.
Однако эти побочные эффекты должны быстро пройти, как только организм привыкнет к лекарству. Современные антигистаминные препараты обычно не вызывают этих побочных эффектов.
Кромогликат натрия - это лекарство, используемое для лечения конъюнктивита, астмы и пищевой аллергии. Его также можно использовать для лечения кишечных симптомов мастоцитоза, но он плохо всасывается из кишечника. Кромогликат натрия является стабилизатором тучных клеток, что означает, что он снижает количество химических веществ, выделяемых тучными клетками. Это помогает облегчить такие симптомы, как диарея, боль в костях, усталость и головная боль. Доступна форма кромогликата натрия, которая наносится на кожу.
Более серьезные симптомы кожного мастоцитоза, такие как сильный зуд кожи, могут потребовать лечения, называемого «псорален плюс ультрафиолет А» или ПУВА. ПУВА предполагает прием лекарства под названием псорален, которое делает человека более чувствительным к УФ-лучам, а затем на кожу воздействуют светом с длиной волны ультрафиолета A, которая помогает уменьшить повреждения кожи. Количество сеансов всегда ограничено, поскольку слишком много ультрафиолета - около 150 сеансов - может увеличить риск развития рака кожи в течение жизни.
Если у пациента диагностирован остеопороз в результате аномальной активности тучных клеток в костях, ему назначат лекарство под названием бисфосфонаты. Бисфосфонаты замедляют процесс разрушения костей, позволяя воспроизводить новые остеоциты в обычном режиме, что улучшает плотность костной ткани.
Первоначально разработанный для лечения рака, интерферон альфа оказался эффективным в лечении некоторых случаев агрессивного мастоцитоза. Точно не известно, как он действует, но похоже, что лекарство снижает производство тучных клеток в костном мозге. Интерферон альфа вводится в виде инъекций. Когда пациент только начнет принимать интерферон альфа, у него могут появиться симптомы гриппа, такие как озноб, высокая температура и боль в суставах. Однако со временем эти симптомы должны улучшиться, как только организм привыкнет к лекарству.
Иматиниб - это лекарство, альтернативное интерферону альфа. Он принимается в виде таблеток и блокирует действие фермента тирозинкиназы, который помогает стимулировать производство тучных клеток. Однако иматиниб следует использовать только тем пациентам, у которых нет мутации KIT, иначе он не работает в большинстве случаев мастоцитоза. Иматиниб также может сделать больного более уязвимым для инфекции.
Если пациент не отвечает на лечение иматинибом, ему могут быть порекомендованы нилотиниб или дазатиниб. Они работают примерно так же, блокируя действие тирозинкиназы.
Изначально кладрибин был разработан для лечения лейкемии, но было доказано, что он полезен при лечении агрессивного систематического мастоцитоза. Кладрибин подавляет активность иммунной системы и вводится путем инфузии. Как и иматиниб, нилотиниб и дазатиниб, кладрибин также сделает пациента более уязвимым к воздействию инфекции, поэтому следует немедленно сообщать о возможных симптомах инфекции своему лечащему врачу.
Системный мастоцитоз с ассоциированным заболеванием крови будет лечиться так же, как и агрессивный систематический мастоцитоз, но с рядом дополнительных методов коррекции соответствующего гематологического состояния.
Перспективы мастоцитоза
У детей симптомы кожного мастоцитоза обычно со временем улучшаются, и во многих случаях состояние регрессирует само по себе к тому времени, когда ребенок достигает половой зрелости. У взрослых же проявления заболевания остаются стабильными длительное время, а иногда и всю жизнь. Перспективы системного мастоцитоза могут варьироваться в зависимости от типа заболевания. Безболезненный системный мастоцитоз не должен влиять на продолжительность жизни, в отличие от других типов мастоцитоза. У некоторых пациентов в течение жизни развивается серьезное заболевание крови, такое как хронический лейкоз.
Тучные невзгоды
Помимо распространенных болезней, которые у всех на слуху, существует немало заболеваний, которые встречаются редко и проявляются нетипично. И приносят много страданий пациентам и головной боли врачам. К таким заболеваниям относится мастоцитоз — онкологическое поражение костного мозга, которое часто выявляют и лечат, когда время уже упущено. Вместе с компанией «Новартис» разбираемся, что оно собой представляет, как появляется, каким бывает и как его правильно лечить.
При мастоцитозе повышается продукция тучных клеток (мастоцитов, одной из разновидностей лейкоцитов). Они выходят в кровь, накапливаются в соединительной ткани различных органов (диффузно или в виде агрегатов) и активируются. Эти клетки служат важным источником медиаторов воспаления и вазоактивных веществ, а также принимают участие в заживлении ран, образовании новых сосудов и аллергических реакциях.
Мастоцитоз встречается редко — по разным источникам, от одного случая на 8000–20000 жителей Земли, независимо от пола и этнической принадлежности. Реальная распространенность может быть выше из-за недостаточной или неверной диагностики. Примерно в 65 процентах случаев заболевание развивается у детей, хотя может возникнуть в любом возрасте. Мастоцитоз может проявляться в кожной и системной формах. Кожная встречается значительно чаще, особенно у детей (около 90 процентов всех случаев).
Загрузить анализы крови и узнать, есть ли в них отклонения, которые могут свидетельствовать о системном мастоцитозе, вы можете на портале Гемогид. Там же вы получите бесплатную информационную консультацию специалиста.
Впервые кожные проявления мастоцитоза описали британские исследователи Эдуард Неттлшип (Edward Nettleship) и Уоррен Тэй (Warren Tay) в 1869 году. Спустя девять лет А. Сэнгстер (А. Sangster) назвал эти проявления пигментной крапивницей.

Пример поражения кожи при системном мастоцитозе
Еще через год знаменитый немецкий иммунолог, бактериолог и химик Пауль Эрлих (Paul Ehrlich) открыл тучные клетки. А в 1887 году его соотечественник и тезка Унна (Paul Unna) на основании клинических и гистологических данных представил подробное описание заболевания.
В 1936 году француз Альбер Сезари (Albert Sézary) и соавторы предложили термин «мастоцитоз», популяризированный в 1953 году Робером Дегосом (Robert Degos). Через 13 лет после публикации Сезари Дж. М. Эллис (J. M. Ellis) впервые описал системную форму заболевания. Всемирная организация здравоохранения (ВОЗ) утвердила терминологию, классификацию и диагностические критерии мастоцитоза лишь в 2001 году.
Классификация мастоцитоза по ВОЗ, 2016
- Макулопапулярный кожный мастоцитоз, или пигментная крапивница.
- Диффузный кожный мастоцитоз.
- Мастоцитома кожи.
- Вялотекущий (индолентный, indolent) системный мастоцитоз.
- Вялотекущий (smoldering) системный мастоцитоз.
- Системный мастоцитоз, ассоциированный с гематологическим заболеванием (не тучных клеток).
- Агрессивный системный мастоцитоз.
- Лейкемия тучных клеток.
Саркома тучных клеток.
В следующем параграфе — подробное описание того, что происходит в организме больного с биологической точки зрения. Если вам интересно узнать, как заметить это заболевание и что, кроме алкоголя и острой пищи, может проявить симптомы, листайте сразу до подзаголовка «Системная диагностика»
Что происходит в организме больного
Несмотря на относительно длительную историю исследований мастоцитоза, механизмы его возникновения и развития пока изучены не полностью. Однако с совершенствованием диагностических методик появляются все новые данные по этому вопросу.
Почти всегда причиной развития мастоцитоза становится точечная мутация гена, кодирующего протоонкогенную рецепторную тирозинкиназу c-kit (CD117, SCFR), которая связывается с фактором стволовых клеток (SCF). Говоря простым языком, более активный рецептор на поверхности мастоцитов и их предшественников в костном мозге вызывает бесконтрольный усиленный рост и созревание этого типа клеток.
Наиболее часто (более 80–95 процентов пациентов с системным мастоцитозом) встречается мутация D816V, однако заболевание могут вызвать и другие полиморфизмы c-kit; на данный момент их известно около 20. Свой вклад в развитие различных форм мастоцитоза и их тяжесть могут вносить и сопутствующие мутации других генов, таких как TET2, SRSF2, ASXL1, RUNX1, JAK2, CBL, NRAS, KRAS и другие. В подавляющем большинстве случаев такие генетические дефекты возникают в соматических (неполовых) клетках после зачатия, поэтому отсутствуют у родственников и не передаются потомству. В единичных случаях заболевание имеет семейную природу и наследуется по аутосомно-доминантному типу, то есть человек с одной дефектной копией гена передаст его ребенку с вероятностью 50 процентов.
Мастоциты с подобными мутациями (перерожденные, неопластические) помимо «родных» мембранных белков — триптазы тучных клеток (MCT) и CD117 — зачастую экспрессируют несвойственные для себя CD25, CD2 и, реже, CD30, CD33, CD52 и/или CD123. Обнаружение этих белков способствует диагностике заболевания. Кроме того, измененные клетки синтезируют поверхностные антигены лекарственной устойчивости, такие как CD47, CD243 и CD274, которые могут стать мишенями для новых препаратов

Иммуногистохимический анализ биоптата костного мозга (увеличение в 400 раз): агрегаты тучных клеток, экспрессирующих мембранный белок CD25
Malisha R Johnson et al. / Modern Pathology, 2009
Мазок аспирата костного мозга (увеличение в 1000 раз, окраска по Райту–Гимзе): атипичная морфология тучных клеток, включая веретенообразные, дегранулированные и гипогранулированные формы
Malisha R Johnson et al. / Modern Pathology, 2009

Иммуногистохимический анализ биоптата костного мозга (увеличение в 40 раз): мультифокальные агрегаты тучных клеток, содержащих триптазу
Malisha R Johnson et al. / Modern Pathology, 2009

Биоптат костного мозга (увеличение в 200 раз, окраска гематоксилином и эозином): крупный агрегат тучных клеток (более 15) с примесью лимфоцитов и эозинофилов
Malisha R Johnson et al. / Modern Pathology, 2009
Дальнейший сценарий, как следует из определения мастоцитоза, очевиден: бесконтрольно размножающиеся клетки выходят в кровь и накапливаются в различных органах. Там они выделяют вазоактивные вещества и медиаторы воспаления: гистамин, гепарин, простагландины, лейкотриены, фактор некроза опухолей α и многие другие, вызывая повреждение тканей. Свой вклад в нарушение функции органов вносит и сдавление накопившимися мастоцитами.
При более распространенной кожной форме их «вторжение» ограничено кожей, что уже достаточно неприятно. При гораздо более редкой, тяжелой и сложной для диагностики системной форме неопластические тучные клетки накапливаются вне кожи, хотя обычно затрагивают и ее. Эта форма часто «маскируется» под кожную или болезни отдельных органов. Поэтому рассмотрим системный мастоцитоз подробнее.
Системная диагностика
Наиболее часто системный мастоцитоз поражает кожу (проявления схожи с кожной формой) и желудочно-кишечный тракт (воспаление; нарушения пищеварения, функции печени и поджелудочной железы). Реже — сердце (тахикардия, сердцебиение, гипотония), легкие (одышка, астмоподобный синдром), нервную систему (когнитивные расстройства, нарушения концентрации внимания и кратковременной памяти, головная боль, депрессия) и кости (остеопороз и переломы). Также может снижаться количество лейкоцитов в периферической крови, что приводит к ослаблению иммунитета и, как следствие, частым инфекциям.
Типичные симптомы системного мастоцитоза неспецифичны и включают:
- покраснение и зуд кожи, пигментные пятна, крапивницу;
- симптом Дарье (возникновение крапивницы в ответ на механическое раздражение кожи);
- дискомфорт, вздутие и боль в животе (в том числе из-за образования язв в желудке вследствие избыточной продукции кислоты);
- расстройства пищеварения;
- тошноту и рвоту;
- диарею;
- увеличение печени, селезенки и лимфоузлов;
- нарушения обоняния;
- воспаление ЛОР-органов;
- боль и дискомфорт в глазах, слезотечение;
- головокружение и обмороки;
- головную боль;
- депрессию;
- когнитивные нарушения;
- боли в опорно-двигательной системе;
- кровотечения;
- анафилаксию.
Эти проявления могут возникать в любом сочетании в зависимости от поражения конкретных органов и систем. Пусковыми факторами появления симптомов могут служить разные вещи, наиболее часто это раздражение кожи, физические нагрузки, алкоголь или острая пища, укусы насекомых и некоторые лекарства.
Диагностика системного мастоцитоза основывается на подробном опросе. Он нужен, чтобы выявить симптомы. Здесь крайне важно внимание пациента к своему телу и самочувствию — оно поможет вовремя заподозрить, что что-то идет не так, и содержательно рассказать об этом специалисту.

Инструментальные методы чаще всего включают биопсию костного мозга и органов-мишеней (при подозрении на их поражение) для поиска агломератов мастоцитов и определения морфологии этих клеток. Анализ биоптата может включать иммуногистохимическое исследование для изучения экспрессии специфических поверхностных белков (CD25, CD2 и других).
Также весьма информативны молекулярные методы диагностики: секвенирование в реальном времени и различные модификации полимеразной цепной реакции. С их помощью определяют мутации, приводящие к развитию заболевания и определяющие тяжесть его течения.
Биохимический анализ крови помогает выявить повышенный уровень триптазы, характерный для системного мастоцитоза, а также маркеры поражения органов (например, увеличение концентрации печеночных ферментов). При общем анализе крови можно увидеть большое число тучных клеток, в том числе измененной формы, и снижение концентрации других форменных элементов.
Оценить поражение органов-мишеней помогают лучевые методы (ультразвуковое исследование, рентгенография, компьютерная и магниторезонансная томографии) и эндоскопия (с биопсией или без нее)
Диагностические критерии системного мастоцитоза
Основной критерий — мультифокальное накопление и кластеризация тучных клеток (15 и более в кластере) в костном мозге или других тканях, кроме кожи.
- нарушенная морфология (например, веретенообразная форма) более чем 25 процентов тучных клеток в биоптате;
- экспрессия CD2 и/или CD25 в тучных клетках костного мозга, крови или внутренних органов;
- экспрессия активирующей мутации кодона 816 гена KIT в костном мозге или внутренних органах;
- базальный уровень триптазы в сыворотке крови более 20 нанограммов на миллилитр (незначимо при сопутствующих гематологических заболеваниях).
Диагноз ставят на основании наличия либо основного и одного малого критериев, либо трех малых критериев.
Усугубляет проблему диагностики то, насколько сильно отличаются разные формы системного мастоцитоза. Подробнее о них читайте в следующем параграфе.
Форма форме рознь
Перечисленные критерии позволяют поставить диагноз, однако отдельные формы системного мастоцитоза имеют свои специфические особенности.
Вялотекущие формы системного мастоцитоза встречаются чаще всего, протекают относительно легко и прогрессируют медленно. Индолентная отличается лишь сравнительно меньшим поражением органов. Для этих форм характерны кожные симптомы, сопутствующих гематологических заболеваний нет.
Системный мастоцитоз, ассоциированный с гематологическим заболеванием (примерно 20 процентов всех случаев), в дополнение к общим диагностическим критериям имеет признаки пролиферативного или диспластического поражения костного мозга. Протекает тяжелее и развивается быстрее вялотекущих форм. Поражения кожи встречаются редко.
Агрессивный системный мастоцитоз наблюдается редко, протекает тяжело с поражением многих органов и систем, прогрессирует быстро. Кожные проявления, как правило, отсутствуют.
Лейкемия тучных клеток — наиболее редкая и злокачественная форма системного мастоцитоза. Характерно большое содержание незрелых тучных клеток в костном мозге (более 20 процентов) и периферической крови (более 10 процентов при лейкемическом варианте и менее — при алейкемическом).
Лечиться эффективно
Радикального лечения системного мастоцитоза, к сожалению, пока не существует, однако имеющиеся методы могут значительно улучшить самочувствие и замедлить течение болезни. Терапия разделяется на симптоматическую (устраняет отдельные проявления заболевания) и циторедуктивную (снижает количество неопластических тучных клеток). Выбор отдельных препаратов зависит от конкретной формы заболевания и его тяжести.
Средства для симптоматической терапии включают:
- антигистаминные препараты (блокируют рецепторы к гистамину, уменьшая его эффекты и, как следствие, аллергические проявления);
- стабилизаторы мембран тучных клеток (снижают выброс цитокинов и вазоактивных веществ мастоцитами, применяются при недостаточной эффективности антигистаминов);
- ингибиторы лейкотриенов (блокируют действие соответствующих медиаторов аллергии и воспаления);
- глюкокортикостероиды (противовоспалительные гормональные препараты действуют сильнее антигистаминных и антилейкотриеновых, хотя и с более выраженными побочными эффектами, применяются при агрессивных формах заболевания либо местно, либо системно — в виде таблеток или инъекций);
- адреналин, он же эпинефрин (вводят вместе с глюкокортикоидами, антигистаминными препаратами и инфузионной терапией для экстренной помощи при анафилактическом шоке), при неконтролируемой анафилаксии используют антагонист иммуноглобулина Е омализумаб;
- другие симптоматические средства назначают при поражениях конкретных органов, например, для снижения кислотности желудочного сока и расширения бронхов.
В циторедуктивной терапии используют:
- интерферон-α (иммунотерапевтический препарат, снижающий степень инфильтрации костного мозга тучными клетками и, соответственно, уменьшающий поражение органов);
- кладрибин (химиотерапевтическое средство, эффективнее интерферона, быстро угнетает рост мастоцитов и, что нежелательно, некоторых других типов клеток);
- ингибиторы тирозинкиназ (селективно блокируют соответствующую группу ферментов, необходимых для продукции тучных клеток, применяются при агрессивных формах системного мастоцитоза, в том числе не связанных с мутациями гена С-KIT).
Редко, в случае неэффективности перечисленных методов терапии, прибегают к трансплантации донорского костного мозга. Для этого подбирают подходящего донора, уничтожают собственный костный мозг пациента химиотерапевтическими препаратами (иногда с добавлением лучевой терапии) и замещают его нормально функционирующими донорскими клетками, не содержащими мутаций.
Лечением всех форм мастоцитоза занимаются гематологи, а в идеале — онкогематологи. Именно к ним следует обращаться при подозрительных симптомах, описанных выше. При этом большинство людей с системным мастоцитозом идут к терапевтам и долго и безуспешно борются с отдельными проявлениями, так и не получив правильный диагноз.
Найти хорошего специалиста проще всего в крупных гематологических центрах и клиниках; помочь в этом могут люди, уже прошедшие лечение, и пациентские организации. Нелишним будет и узнать «второе мнение» — посетить нескольких специалистов и выслушать их рекомендации.
Найти подходящую клинику с привязкой к карте, а также получить информацию о пациентских организациях можно на сайте Гемогид.
При правильном лечении пациенты с вялотекущими формами системного мастоцитоза обычно живут не меньше тех, кто не страдает этим заболеванием. При более агрессивных формах заболевания продолжительность жизни и ее качество зависят от степени поражения органов; того, как быстро человек обратился к врачу и получил правильный диагноз; эффективности лечения и компетентности лечащего врача.
Если все сложится лучшим образом, «тучные невзгоды» не помешают прожить долгую и полноценную жизнь. Но тут важно упомянуть, что главный фактор, который позволяет спасти жизнь и повысить ее качество, — внимание самого пациента к своему телу и небоязнь выяснить, что с ним происходит, если назначенное лечение не помогает.
Мастоцитоз
Мастоцитоз – инфильтрация тучными клетками кожи и других тканей и органов. Симптомы, главным образом, являются следствием высвобождения медиаторов и среди них выделяют зуд, покраснение и диспепсию, вследствие желудочной гиперсекреции. Диагноз ставится на основании биопсии кожи, костного мозга или, и того, и другого вместе. Лечение заключается в назначении антигистаминных препаратов и контроля за основным заболеванием.
Мастоцитоз – группа заболеваний, характеризующаяся пролиферацией тучных клеток и инфильтрацией ими кожи и других органов. Патогенез основан, главным образом, на высвобождении медиаторов тучных клеток, включая гистамин, гепарин, лейкотриены и различные цитокины воспаления. Гистамин является причиной многих симптомов, включая симптомы со стороны ЖКТ, но другие медиаторы также участвуют. Значительная инфильтрация органа приводит к его дисфункции. Высвобождение медиаторов запускается через физический контакт, физическую нагрузку, алкоголь, нестероидные противовоспалительные препараты (НПВП), опиоиды, укусы жалящих насекомых или пищу.
Этиология неизвестна, но может включать активацию процесса мутации (D816V) гена, кодирующего рецептор тирозинкиназы (c-kit) фактора стволовых клеток, присутствующего на тучных клетках. В результате возникает аутофосфорилирование рецептора, что вызывает неконтролируемую гиперпродукцию тучных клеток.
Классификация мастоцитоза
Мастоцитозы подразделяются на кожные и системные.
Мастоцитоз кожи
Мастоцитоз кожи обычно проявляется у детей. У большинства пациентов наблюдается пигментная крапивница, локальная или диффузная оранжево-розовая (цвета лососины) или коричневая пятнисто-папулезная кожная сыпь, которая является следствием множественных мелких скоплений тучных клеток. Также могут развиваться узловые повреждения и бляшки. Более редкими формами являются диффузный кожный мастоцитоз, который проявляется инфильтрацией кожи тучными клетками без дискретных поражений, и мастоцитома с крупными единичными (от 1 до 5 см) скоплениями тучных клеток.
У детей кожная форма редко прогрессирует в системную, но у взрослых такие случаи могут наблюдаться.

Поражения состоят из красновато-коричневых, нерегулярных бляшек, которые при трении вызывают ощущение жжения (симптом Дарье).
С разрешения издателя. Из Joe E, Soter N. В Current Dermatologic Diagnosis and Treatment , edited by I Freedberg, IM Freedberg, and MR Sanchez. Philadelphia, Current Medicine, 2001.
Младенец, показанный на этом фото, имеет обильные папулонодулярные и бляшечные очаги пигментной крапивницы.
© Springer Science+Business Media
На фотографии показаны красновато-коричневые пятна на спине у ребенка школьного возраста.
© Springer Science+Business Media
На этом изображении показаны желтовато-коричневый или красновато-коричневый пятна и папулы, возникающие при пигментной крапивнице.
Изображение предоставлено Карен Мак-Коу (Karen McKoy), доктором медицины
Пигментная крапивница может проявляться в виде красноватых бляшкоподобных образований на коже.
© Springer Science+Business Media
Системный мастоцитоз
Системный мастоцитоз чаще встречается у взрослых и характеризуется мультифокальными поражениями костного мозга; часто поражаются и другие органы, а именно – кожа, лимфоузлы, печень, селезенка или желудочно-кишечный тракт.
Системный мастоцитоз классифицируется как:
Безболезненный мастоцитоз, без органной дисфункции и с благоприятным прогнозом
Мастоцитоз, ассоциированный с другими гематологическими нарушениями (например, миелопролиферативными нарушениями, миелодисплазией, лимфомой)
Агрессивный мастоцитоз, характеризующийся значительной органной дисфункцией
Тучно-клеточная лейкемией с более, чем с 20% тучных клеток в мазке костного мозга, без поражения кожи, но с мультиорганными поражениями и неблагоприятным прогнозом
Симптомы и признаки мастоцитоза
Поражение кожи при мастоцитозе характеризуется зудом, причём вне зависимости от того, единичная ли это мастоцитома, или диффузное заболевание. Усугубление зуда возможно по следующим причинам:
Контакт с одеждой или другими материалами
Использование некоторых препаратов (включая НПВП)
Потребление горячих напитков, пряных продуктов или алкоголя
Поглаживание или растирание поражений кожи является причиной появления крапивницы и эритемы вокруг места поражения (симптом Дарье); эта реакция отличается от дермографизма, вызывающего поражение нормальной кожи.
Системные симптомы очень разнообразны. Наиболее часто отмечаются приступы лихорадки; тяжелыми являются анафилактические реакции с обмороками и шоком.
Среди других симптомов отмечаются эпигастральные боли в связи с язвенной болезнью, тошнота, рвота, хроническая диарея, артралгии, боли в костях, нейропсихиатрические изменения (например, раздражительность, депрессия, лабильность настроения). Инфильтрация печени и селезенки может привести к портальной гипертензии с последующим асцитом.
Диагностика мастоцитоза
Биопсии участков пораженной кожи и, при необходимости, костного мозга
Мастоцитоз диагностируют на основании клинических признаков. Диагноз подтверждается биопсиями участков пораженной кожи и, при необходимости, костного мозга. Присутствуют многоочаговые плотные инфильтраты тучных клеток.
Мочевая экскреция 5-гидроксииндолуксусной кислоты (5-ГИУК), для исключения карциноидного синдрома Карциноидный синдром Карциноидный синдром, наблюдающийся у некоторых людей с карциноидными опухолями, характеризуется покраснением кожи (горячие приливы), спазмами в животе и поносом. Через несколько лет может развиться. Прочитайте дополнительные сведенияЗдравый смысл и предостережения
Следует исключить расстройства, имеющие симптоматику, схожую с мастоцитозом (например, анафилаксию, карциноидный синдром, феохромоцитому, синдром Золлингера-Эллисона).
При трудностях в постановке диагноза измеряются уровни медиаторов тучных клеток и их метаболитов (мочевого N-метилгистамина; N-метилмедазол-уксусной кислоты) в плазме крови и моче; повышение уровней подтверждает диагноз мастоцитоза. Уровни триптазы (маркера дегрануляции тучных клеток) повышены при системном мастоцитозе, но обычно нормальны при кожном мастоцитозе.
Сканирование костного мозга, обследование желудочно-кишечного тракта, выявление мутации D816Vc-kit также полезны в случаях, когда диагноз требует дополнительного подтверждения.
Лечение мастоцитоза
При агрессивных формах – интерферон альфа-2b, глюкокортикоиды или спленэктомия
Мастоцитоз кожи
Мастоцитома обычно проходит самостоятельно и не требует лечения.
Системный мастоцитоз
Все пациенты должны принимать H1- и H2-блокаторы и иметь при себе наполненный адреналином шприц для самостоятельного проведения инъекции.
Аспирин помогает в случае повышения температуры, но может увеличивать продукцию лейкотриенов, таким образом, способствуя развитию других симптомов, связанных с самими тучными клетками; его не назначают детям из-за большого риска развития синдрома Рея.
Больным с агрессивными формами течения назначается интерферон альфа-2b 4 млн единиц подкожно 1 раз в неделю либо максимальная доза 3 млн единиц в день для купирования костных поражений. Могут потребоваться глюкокортикоиды (преднизон от 40 до 60 мг 1 раз в день в течение 2–3 недель). По некоторым ограниченным данным предполагается, что спленэктомия может улучшить выживаемость у пациентов с агрессивным течением заболевания.
Основные положения
У пациентов с мастоцидозом кожи, как правило у детей, обычно присутствует диффузная лососево-розовая или коричневая пятнисто-папулезная кожная сыпь.
Системные мастоцитозы вызывают многоочаговые поражения костного мозга, обычно у взрослых, часто поражаются другие органы.
Все типы вызывают системную симптоматику (чаще всего – лихорадку, но иногда и анафилатические реакции).
Убедитесь, что все больные мастоцитозом имеют при себе шприц для самостоятельного выполнения инъекций, наполненный адреналином.
Авторское право © 2022 Merck & Co., Inc., Rahway, NJ, США и ее аффилированные лица. Все права сохранены.
Читайте также:
